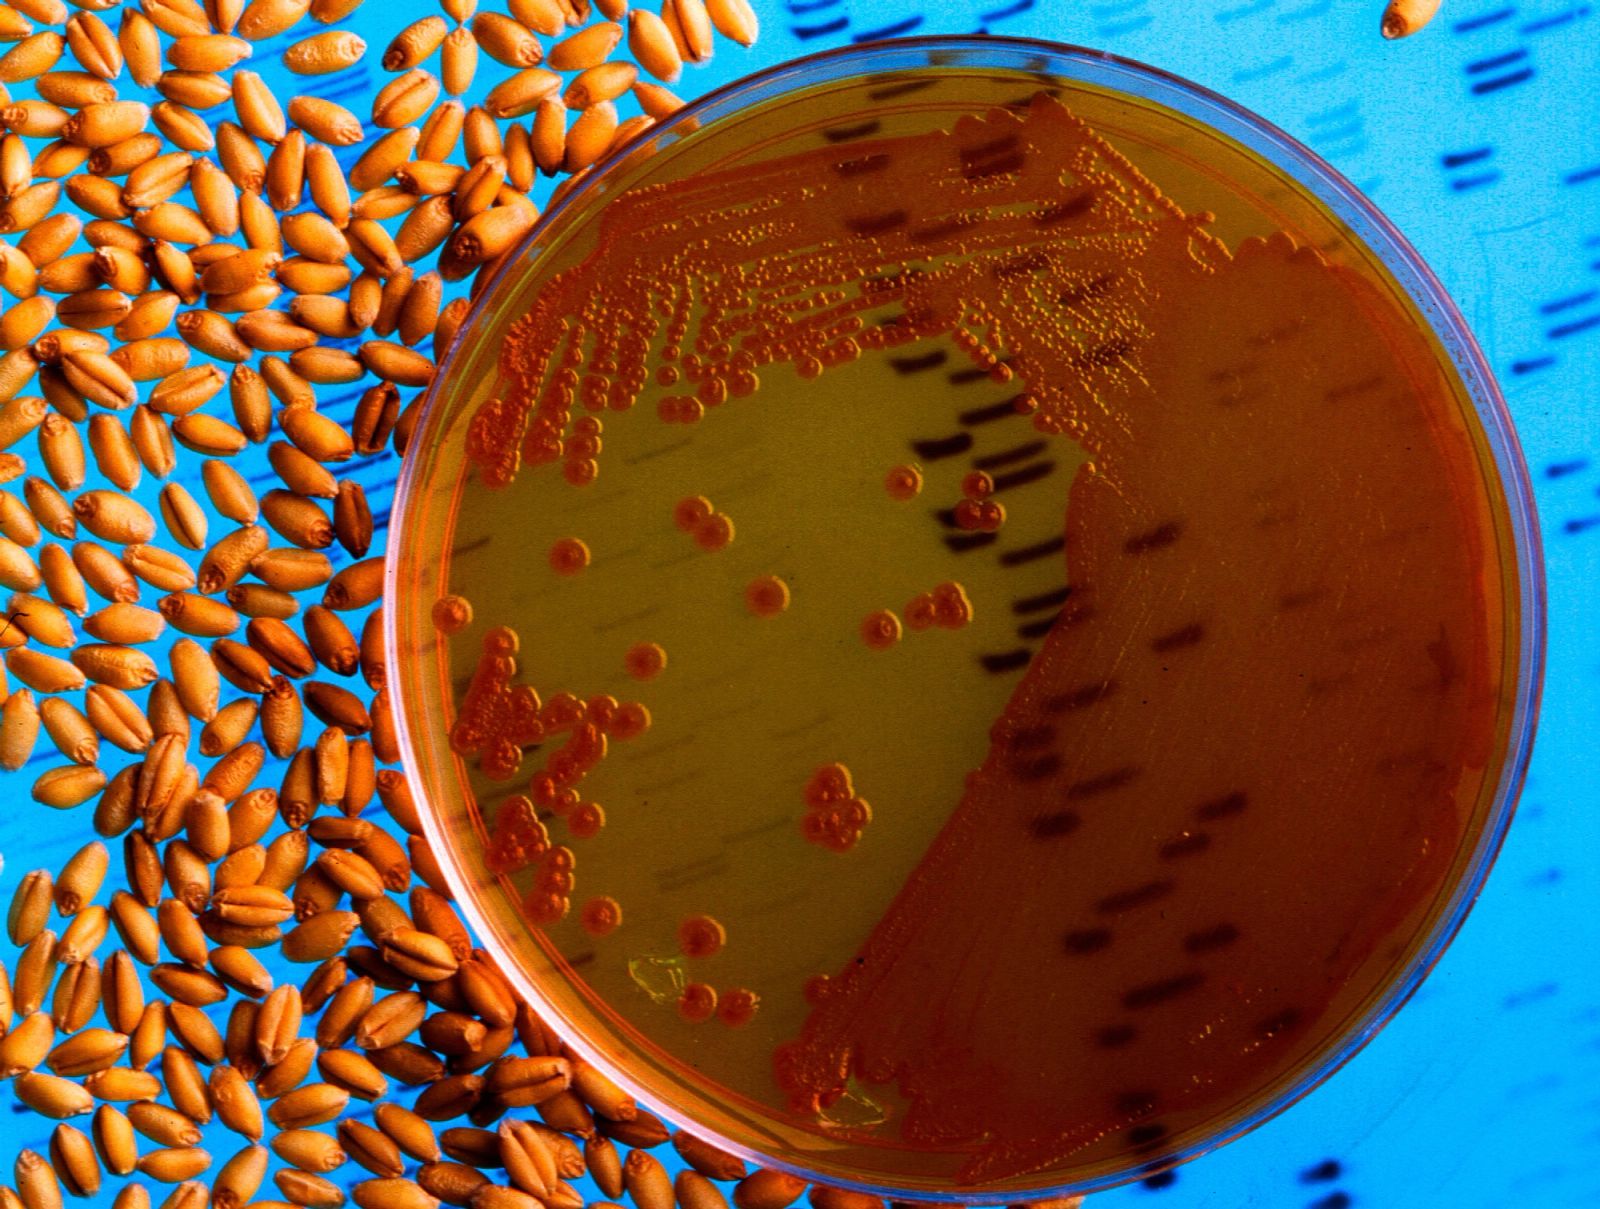

QuizViten
Genteknologiske spørsmål
1. Hva kalles vanligvis genteknologi på engelsk?
Les hele Klassekampen på nett
Få nyhetene som setter dagsorden, analysene som betyr noe og stemmene som teller. Abonner i dag.
Bli abonnentFå nyhetene som setter dagsorden, analysene som betyr noe og stemmene som teller. Abonner i dag.
Bli abonnent